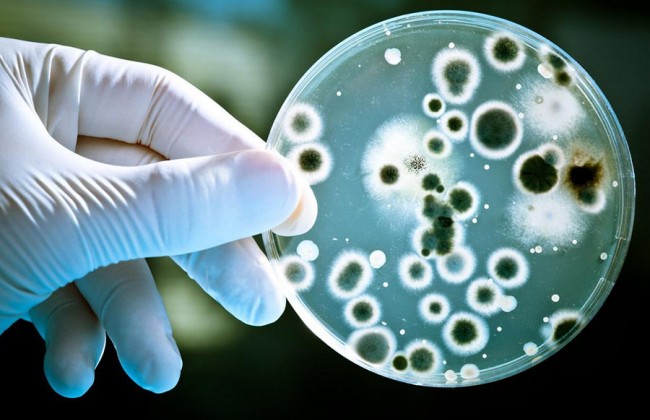
Вирус Коксаки: что нужно знать, чтобы не подцепить смертельную инфекцию

Вирус Коксаки: что нужно знать, чтобы не подцепить смертельную инфекцию
Вирус может поразить, как детей, так и взрослую категорию населения.
Об этом передает Голос.ua.
По словам врача-педиатра клиники «Борис», Коксаки относится к так называемым энтеровирусам. Такой вирус существует давно, и он будет существовать и далее.
По словам эксперта, он также может встретиться и в предзимнее время, и в зимнее. Отмечается, что в зимний период пациентов относительно меньше, нежели в другие времена года.
У детей вирус проявляется следующим образом:
- может возникнуть высокая температура;
- образование пузырьков на слизистой оболочке рта и вокруг него;
- пузырьки также могу появиться на ладонях и пятках.
Что касается взрослых, то у них высыпаний меньше или они вообще не характерны.
Они могу перенести вирус просто с высокой температурой и покраснением в горле.
Как сообщает сотрудник больницы, чтобы побороть вирус, не нужны особые препараты.
Необходимо использовать только симптоматическую терапию: сбивать температуру и больше пить.
Также необходим контроль педиатра, для того чтобы не случилось поражения центральной нервной системы и сердца.
Отмечается, что вирусом Коксаки можно заразиться не только в Турции.
По словам врача, такой вирус распространен и в Украине, это базовая вирусная инфекция.
Напомним, как ранее писала «Судебно-юридическая газета», МИД Украины поручил посольству в Турции проработать целесообразность рекомендаций из-за вируса Коксаки.







































